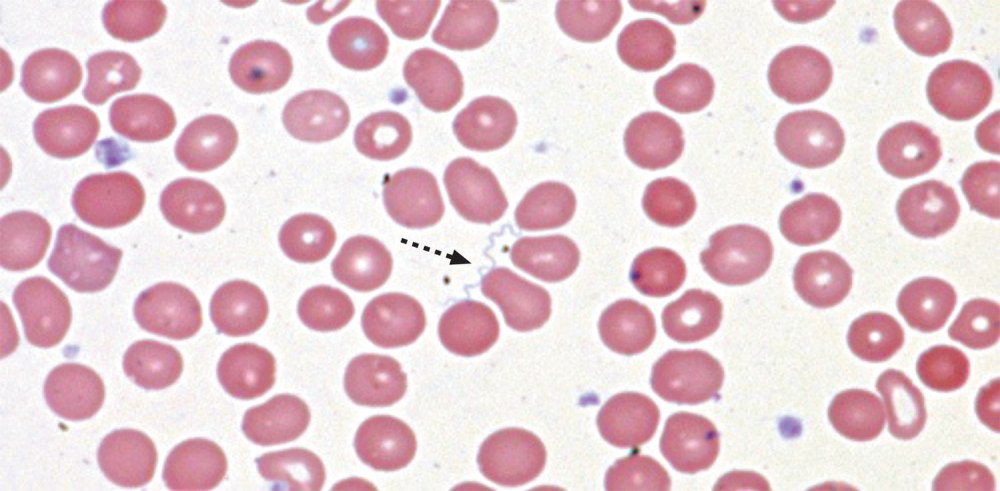

Бактерии боррелии

---

Извитые бактерии спирохеты

Бактерия рода Borrelia burgdorferi спирохета

Treponema pallidum темнопольная микроскопия

Боррелиозы микробиология исследуемый материал

Спирохета Обермейера

Боррелии грамотрицательные

Спириллы бактерии

Патоген трепонема

Спирохеты боррелии

Borrelia burgdorferi микроскопия

Боррелия бургдорфери микроскопия

Возвратный тиф бактерия

Спирохета Обермейера

Бледная трепонема под микроскопом


Borrelia recurrentis (спирохета Обермейера)

Иксодовый клещевой боррелиоз возбудитель

Стебельковые бактерии микробиология

• Боррелии (b.burgdorferi, в.garinii в.afielii)

Бактерия боррелия рисунок

Боррелия бургдорфери микроскопия

Боррелия бургдорфери микробиология

Паразиты живущие внутри крови человека


Caulobacter crescentus

Палочки бациллы грамположительные

Возвратный тиф бактерия

Спирохеты боррелии

Спирохеты, боррелии, лептоспиры

Боррелия бургдорфери микроскопия

Боррелия бургдорфери микроскопия

Боррелия бургдорфери микробиология


Боррелия бургдорфери микробиология

Спирохета боррелия возбудитель

Риккетсии Романовский Гимза

Сенная палочка

Боррелия микробиология


Спирохета рода боррелия

Спирохета боррелия возбудитель

Белок боррелий


Боррелия бургдорфери микробиология


Бактерия рода Borrelia burgdorferi спирохета

Borrelia garinii микробиология


Спириллы бактерии

Восприимчивость к красителям боррелии



Трепонема Романовскому Гимзе

Боррелии возвратного тифа микробиология

Бактериемия при боррелии возвратного тифа

Боррелии грамотрицательные

Боррелия бургдорфери возбудитель

Трепонема Романовскому Гимзе

Ферменты боррелий

Спирохета рода боррелия

Боррелия морфология

Борелия Garini

Бореллия в крови больного

Боррелии форма клетки
Borrelia по Романовскому Гимзе

Клещевой энцефалит бактерия

Borrelia рисунок

Borrelia garinii микробиология

Боррелия бургдорфери возбудитель

Спириллы под микроскопом

Боррелиоз Лайма возбудитель

B burgdorferi под микроскопом

Leptospira biflexa бактерия форма

Бледная трепонема возбудитель

Спирохеты боррелии


Филумы бактерий